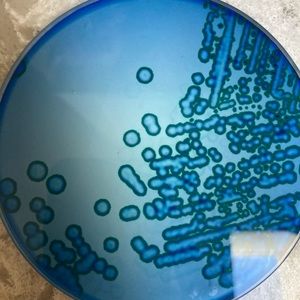
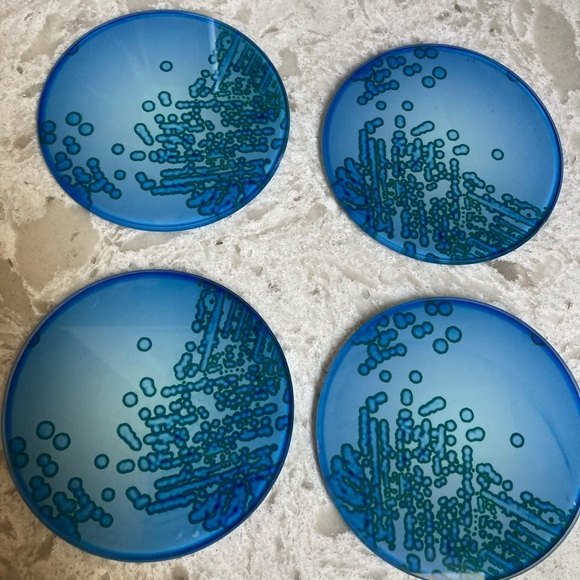

4 Blue Glass “molecular” coaster
C$24
Size
Not for sale
Like and save for later
4 blue glass coasters, with molecular detail
New, from Science Museum, London
Like peering into a microscope
Non smoking home
Color
Shipping/Discount





chantalprove679
and
12 others
like this
Trending Now
Find Similar Listings
Account is under Review
Comment posting is temporarily restricted. Our team will reach out to you shortly. To understand why, select
Learn More.